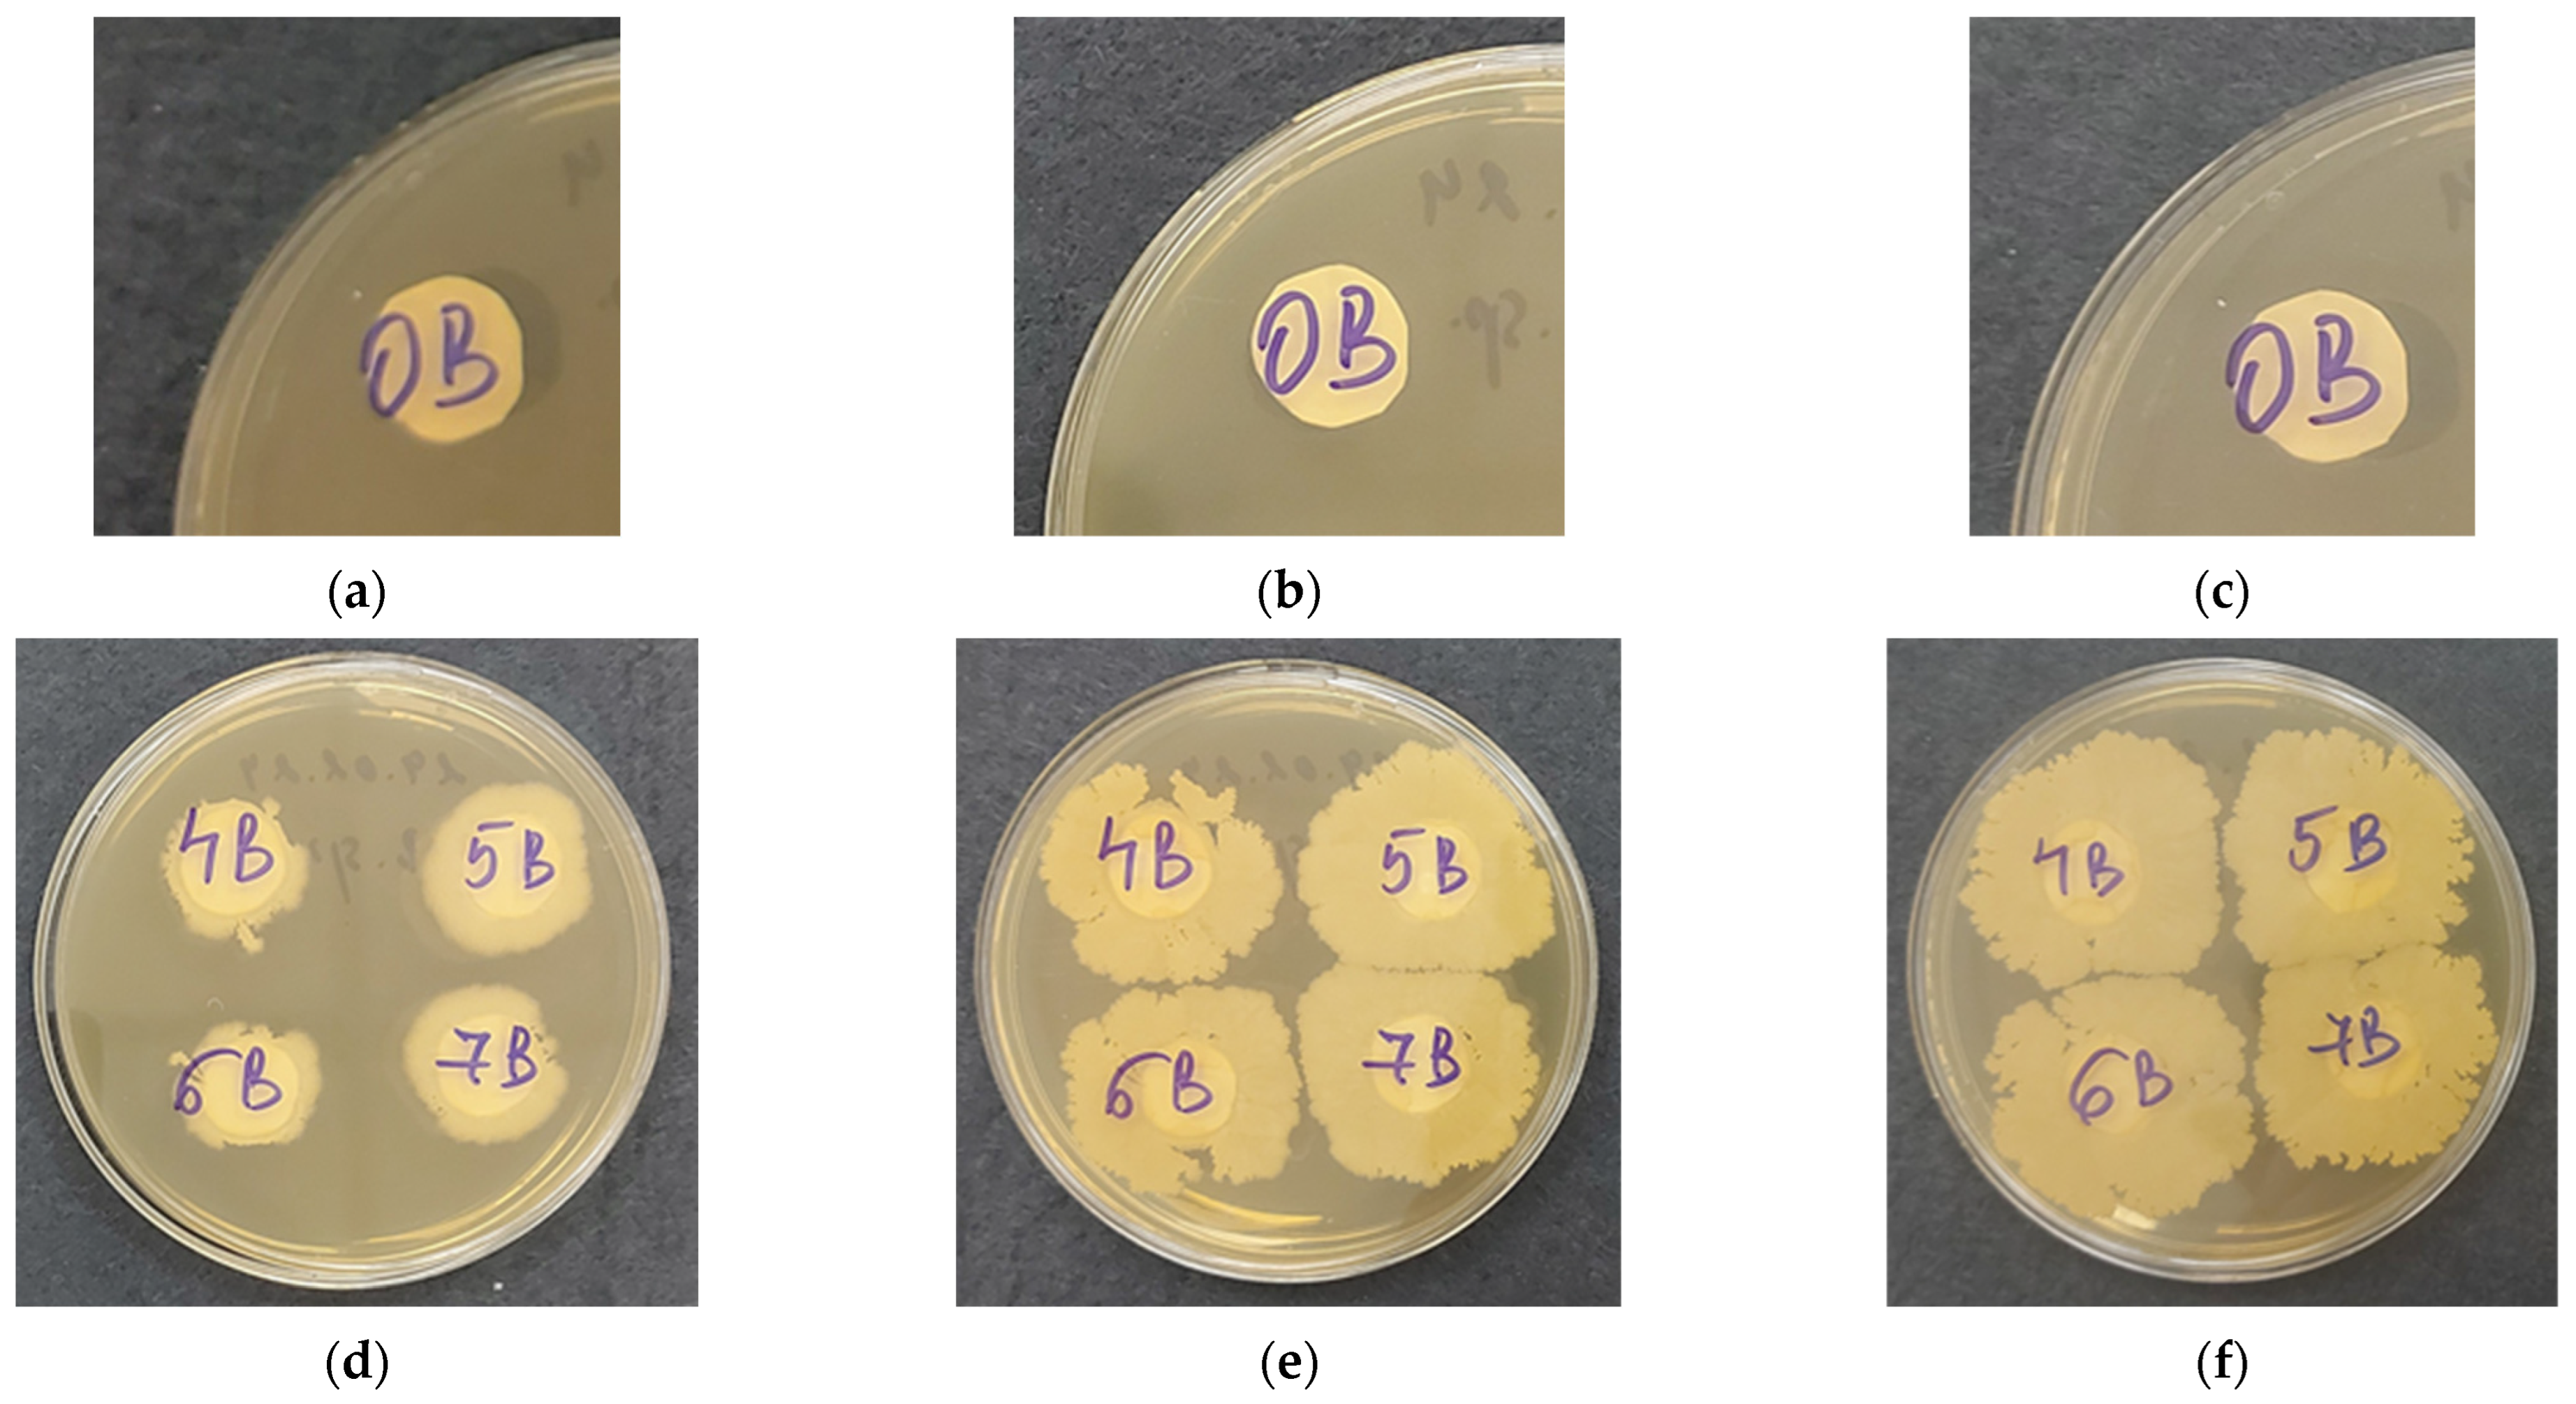
Polymers 16 02749 g007

Recently, we prepared electrospun poly(L-lactide) (PLLA) materials coated with chitosan as carriers for encapsulation of beneficial fungus
T. asperellum and showed that these hybrid nanomaterials hamper the growth of the pathogenic
P. chlamydospora and
P. aleophilum fungi [
22]. In this study, novel biohybrid materials were obtained as effective biocontrol formulations for plant protection and growth promotion, using the Gram-positive soil bacterium
Bacillus subtilis as the biocontrol agent. Electrospun poly(3-hydroxybutyrate) (PHB) was selected as the polymer carrier due to its microbial origin, biodegradability, biocompatibility, and excellent mechanical properties, which are comparable to those of polypropylene [
23]. In addition, a simple, low-cost, reliable, and reproducible dip-coating method was employed to form thin films on the electrospun PHB fibers (
Scheme 1). This method preserves the desired fiber structure and facilitates the encapsulation of the beneficial bioagent. The dip-coating, utilizing water-soluble, biocompatible, and biodegradable natural cellulose derivatives, creates a favorable environment for the biocontrol agent, ensuring its survival during storage and normal development when introduced into an environment for plant growth or in the presence of moisture. Through this straightforward and innovative approach, the targeted biohybrid materials, based on dip-coated electrospun PHB fibers, were developed as effective biocontrol formulations.
3.1. Morphological and Structural Characterization of Electrospun PHB Materials Coated with Cellulose Derivatives
Preliminary experiments were conducted to determine the optimal viscosity and concentration of the aqueous cellulose derivative solutions required to form a uniform thin film during dip-coating. The dynamic viscosities of the prepared aqueous solutions of CMC-Na, HEC-L, HEC-M, and HEC-H at a selected concentration of 0.5 wt% were subsequently measured. As anticipated, the solution viscosity increased with the molecular weight of the cellulose derivatives, following this order: HEC-L (10 cP) < CMC-Na (19 cP) ≈ HEC-M (20 cP) < HEC-H (38 cP).
The surface morphology of the obtained electrospun PHB materials, both before and after dip-coating in aqueous CMC-Na, HEC-L, HEC-M, and HEC-H solutions, was observed using SEM (
Figure 1). The electrospinning of the PHB solution under the selected conditions prior to dip-coating resulted in the formation of uniform, defect-free cylindrical fibers without pores along their length (
Figure 1a). Following dip-coating, the fiber structure remained intact, although some clumping of the fibers was observed (
Figure 1b–e). This clumping is attributed to the deposition of a thin film of cellulose derivatives on the PHB fibers, which acts as an adhesive. The formation of this film over and between the PHB fibers is clearly visible in the SEM images (
Figure 1b–e, insets). Additional evidence for the film formation is provided by the changes in mean fiber diameters measured before and after the dip-coating. Consistent with our previous findings, the mean PHB fiber diameter before dip-coating was 120 ± 22 nm [
21]. After dip-coating with cellulose derivatives of varying molecular weights, the average diameters of the PHB fibers were as follows: 145 ± 25 nm for PHB/CMC-Na, 130 ± 23 nm for PHB/HEC-L, 150 ± 27 nm for PHB/HEC-M, and 165 ± 30 nm for PHB/HEC-H. The fiber diameter distribution was also determined and is presented in
Figure S2. The increase in mean fiber diameter after coating is clearly due to the film deposition. As expected, the molecular weight of the cellulose derivatives also influenced the results, reflecting the different viscosities of the aqueous solutions.
ATR-FTIR spectroscopy was used for qualitative analysis and to observe changes in the chemical structure of the electrospun PHB materials before and after dip-coating. The FTIR spectra of the electrospun PHB/CMC-Na materials were compared with those of pristine CMC-Na (powder) and electrospun PHB mats (
Figure 2). The spectrum of pristine CMC-Na (powder) showed characteristic absorption bands at 1591 cm⁻
1 and 1420 cm⁻
1, corresponding to the asymmetric and symmetric stretching of –COONa. Additionally, an absorption band at 1325 cm⁻
1, indicative of −OH bending vibrations, and a stretching band at 1051 cm⁻
1 from the ether group (C–O–C) in the glucopyranose structure were also observed. In the representative spectrum of the PHB mat, the absorption peak at 1720 cm⁻
1 corresponds to the C=O stretching band, while the peak at 1279 cm⁻
1 is associated with –CH bending in the polymer chain. An absorption band at 1055 cm⁻
1, attributed to C–O–C stretching, was also observed. In the FTIR spectrum of the PHB fibers coated with CMC-Na, the band at 1720 cm⁻
1, characteristic of the C=O stretching in PHB, is still present. However, the characteristic carbonyl stretching band shifts to 1600 cm⁻
1, compared to 1593 cm⁻
1 in the CMC-Na spectrum. This shift indicates the formation of a thin CMC-Na film on the PHB fibers and suggests hydrogen bonding between functional groups of PHB and CMC-Na.
In addition, the FTIR spectrum of the electrospun PHB mat coated with HEC-M was compared to that of pristine HEC-M (powder) and electrospun PHB fibers (
Figure 3). The characteristic absorption peaks for HEC at 1570 cm⁻
1 and 1404 cm⁻
1 are attributed to O–H plane deformation and C–H symmetric bending vibrations, respectively. A stretching band at 1064 cm⁻
1, corresponding to the ether group (C–O–C) in the glucopyranose structure, was also observed. Moreover, a broad absorption peak at 3392 cm⁻
1 due to O–H stretching vibrations and another peak at 2874 cm⁻
1 from C–H stretching vibrations were detected (
Figure S1). After coating the electrospun PHB fibers with HEC-M, characteristic peaks for both PHB and HEC were observed, indicating successful film formation. The characteristic PHB peak at 1720 cm⁻
1, corresponding to the ester carbonyl group, and the peak at 1279 cm⁻
1, associated with –CH bending in the polymer chain, were present. Simultaneously, HEC-specific peaks appeared, including a broad peak at 3392 cm⁻
1, a peak at 2874 cm⁻
1 (
Figure S1), and the 1064 cm⁻
1 peak assigned to C–O–C stretching in the glucopyranose structure of HEC (
Figure 3). These FTIR analysis results confirm the successful coating of PHB fibers with thin films of cellulose derivatives.
The ability to design and control the surface wettability of the prepared fibrous PHB materials is crucial for their future applications. Morphological and structural analyses have demonstrated the successful coating of the PHB mats with cellulose derivative films, suggesting a change in their wettability. Specifically, a material surface that is easily wetted could either release or provide a conductive environment for encapsulated bioagents. To assess this, the water contact angle of the prepared PHB materials was measured, and the shape of the water droplet deposited on their surfaces was captured.
The molecular weight of the cellulose derivatives affects the contact angle by influencing surface energy, polymer chain orientation, and usually higher molecular weight derivatives leading to more hydrophobic surfaces. In high molecular weight materials, the cellulose chains may orient themselves in such a way that more hydrophobic functional groups are exposed on the surface, increasing the contact angle. Conversely, lower molecular weight derivatives might lead to a more hydrophilic surface due to less chain orientation, resulting in a lower contact angle and greater wettability.
Digital images of water droplets on the surface of the PHB mat, as well as those coated with different cellulose derivatives, along with the corresponding contact angle values, are shown in
Figure 4. As observed, the surface of the electrospun PHB mat is hydrophobic, with a water contact angle of approximately 97°. The water droplets on the PHB mat surface are round and do not spread (
Figure 4a). In contrast, the electrospun PHB mats coated with cellulose derivatives are hydrophilic, with a water contact angle of 0° (
Figure 4b–e). The significant decrease in water contact angle is attributed to the film-forming of CMC-Na and HEC onto PHB mats. In addition, the contact angle for all coated fibrous mats was found to be independent of the molecular weight of the cellulose derivative used. The water droplets were absorbed immediately upon contact with the coated PHB surface, indicating that PHB mats coated with CMC or HEC exhibit superhydrophilic properties.
3.2. Effect of a Cellulose Derivative Coating on the Mechanical Properties of Electrospun PHB Materials
The effect of a cellulose derivative coating on the mechanical properties of electrospun PHB materials was investigated through tensile tests. Recently, we have demonstrated that electrospun PHB samples cut in the direction of collector rotation (0°) exhibited superior mechanical properties [
24]. Therefore, in this study, all PHB specimens were cut in the direction of collector rotation.
The molecular weight and viscosity of cellulose derivatives play key roles in determining the mechanical properties of the material, where higher molecular weight and viscosity lead to stronger, more resilient structures. Viscosity is influenced by molecular weight—higher molecular weight derivatives typically form more viscous solutions. In coating process, high-viscosity solutions can lead to thicker fibers or coatings, which may enhance tensile strength and elasticity. Conversely, lower viscosity solutions can result in thinner fibers with less mechanical resilience.
The resultant stress–strain curves of the electrospun PHB materials before and after coating with cellulose derivatives are shown in
Figure 5. The uncoated electrospun PHB mat exhibited a tensile strength of 4.45 MPa, consistent with previously reported values [
21]. The coating process significantly enhanced the mechanical properties of the electrospun PHB materials, as indicated by curves 2, 3, 4, and 5 in
Figure 5. The molecular weight of the cellulose derivatives, specifically CMC-Na and HEC, had a substantial impact on the mechanical characteristics of the electrospun PHB materials. As the molecular weight of the cellulose derivative increased, so did the tensile strength, following the order: HEC-L (5.2 MPa) < CMC-Na (6.24 MPa) ≈ HEC-M (6.23 MPa) < HEC-H (8.4 MPa). Notably, coating the electrospun PHB materials with high molecular weight HEC resulted in a twofold increase in tensile strength compared to the uncoated PHB mat. Thus, the dip-coating of electrospun materials, followed by film formation, proves to be an effective approach for significantly improving the mechanical properties of electrospun materials.
3.3. Morphological Characterization of Electrospun Biohybrid Materials
Bacillus subtilis is a Gram-positive, catalase-positive bacterium with a rod-shaped structure capable of forming tough, protective endospores, which allow it to withstand extreme environmental conditions. It is one of the most efficient bacteria for producing secreted enzymes, making it widely used by biotechnology companies on a large scale. Before the advent of antibiotics, B. subtilis cultures were popular in alternative medicine as an immunostimulatory agent, aiding in the treatment of gastrointestinal and urinary tract diseases. In agriculture, this bacterium is employed as a soil inoculant and has been found to be an effective bioproduct fungicide. Given these benefits, and with the aim of fabricating effective biocontrol formulations for sustainable agricultural applications, this study presents the first successful encapsulation of B. subtilis into electrospun PHB materials coated with cellulose derivatives. The dip-coating method used preserves the desired fibrous structure of the polymer carrier, enhances mechanical properties, and facilitates the encapsulation of this beneficial microorganism.
Additionally, the applied cellulose derivative coating provides a viable environment for the encapsulated bioagent during storage and transportation, ensures its survival in the target environment, and supports its normal development in the presence of moisture. Schematic representation of the encapsulation of
Bacillus subtilis in cellulose derivative coatings onto PHB mats is shown in
Scheme 1.
The distribution and concentration of Bacillus subtilis cells on PHB mats coated with different cellulose derivatives are driven by multiple factors, including the viscosity and molecular weight of the coating solution, the adhesion properties of the derivative, surface morphology, nutrient diffusion, and interactions between the coating and the PHB substrate. The molecular weight and viscosity of cellulose derivatives contribute to a more controlled and uniform distribution of B. subtilis cells by limiting cell mobility during encapsulation. High-viscosity solutions provide a more uniform environment for the distribution of B. subtilis cells within the electrospun PHB material. The increased viscosity reduces the mobility of the cells during encapsulation, leading to a more controlled and even distribution. In contrast, low-viscosity solutions may allow cells to move freely before the material sets, potentially leading to uneven distribution or clustering.
The morphology of the
B. subtilis cultures was observed using SEM (
Figure 6a,b). The bacterial spores are rod-shaped, measuring 1.474 ± 0.164 µm in length and 0.729 ± 0.887 µm in diameter. As mentioned, after dip-coating the electrospun PHB materials with aqueous cellulose derivative solutions containing a suspension of
B. subtilis, the appearance of spores on the PHB surface was observed (
Figure 6c–f). The number of cells determined from the SEM micrographs per 14,000 μm
2 on the PHB mats coated with cellulose derivatives was approximately 470 cells on the PHB mat coated with CMC-Na/
B. subtilis and 350, 520, and 1185 cells on PHB mats coated with HEC-L/B. subtilis, HEC-M/
B. subtilis, and HEC-H/
B. subtilis, respectively. It is evident that coating with CMC-Na, HEC-L, and HEC-M results in a uniform distribution of cells on the PHB fibers. As the molecular weight increases, besides an overall increase in cell distribution, there are zones with higher concentrations where the polysaccharide film is thicker. The PHB mat saturated with the most
B. subtilis bacteria is the material coated with HEC-H, where the molecular weight and viscosity of the corresponding solution are the highest. In this case, a very dense, uniform film consisting of bacterial cells is formed (
Figure 6f). Nevertheless,
B. subtilis is visibly present in all fibrous PHB materials coated with cellulose derivative films.
3.4. Viability of B. subtilis in Electrospun Biohybrid Materials
After successfully encapsulating Bacillus subtilis in electrospun PHB materials, it was crucial to verify whether the bacterial cells remained viable and could grow normally. To assess this, cell viability tests were conducted by placing the PHB mats coated with cellulose derivatives/B. subtilis films on agar plates.
The multi-timepoint approach was used to ensure a comprehensive assessment of the growth dynamics and viability of B. subtilis within the biohybrid material, covering the entire bacterial growth cycle from early division to long-term survival and adaptation. Early growth-phase measurements at 18 h capture early bacterial growth and adaptation to the biohybrid material. The timepoint at 48 h is a critical phase for understanding bacterial–material interactions, assessing bacterial viability and growth, and providing insights into how well the biohybrid material is supporting sustained bacterial activity over time. The 72 h timepoint is crucial for assessing the long-term compatibility of the biohybrid material with bacterial cells and provides insights into its long-term viability and survival.
Digital images of
B. subtilis growth at 18, 48, and 72 h of incubation are shown in
Figure 7. As expected, no growth was observed around the control electrospun PHB mat. After 18 h, initial growth was detected around the samples coated with cellulose derivatives/
B. subtilis, with slightly less growth observed around the electrospun PHB mat coated with CMC-Na/
B. subtilis. By 48 h,
B. subtilis continued to grow in all samples, and by 72 h, the bacterial cells had spread across the entire Petri dish. These results confirm that the bacterial cells remain viable within the cellulose derivative films and are capable of normal growth from the hybrid materials.